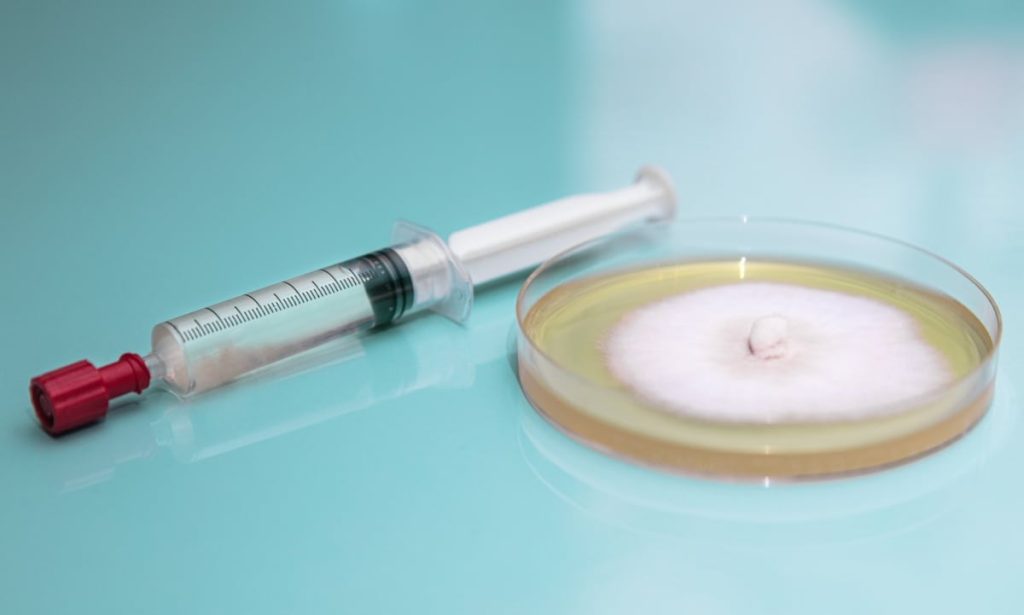
Mushroom culture and mycelium growing in an agar plate

Scan the WeChat code to contact us

Scan the WeChat code to contact us



蘑菇孢子是真菌产生的微小单细胞繁殖结构,通过孢子传播到新的食物来源。
人们常说孢子像植物种子,它们的名称来源于希腊语 sporā,意思是“种子”。但尽管它们的用途相同,孢子与种子并不相同。
植物种子都含有生长一株新植物所需的全部遗传物质。但蘑菇孢子只含有产生新真菌所需遗传物质的一半。
同一种真菌的两个孢子必须相遇并融合才能产生新的蘑菇菌种。
另一个区别是,大多数植物种子肉眼可见,而蘑菇孢子是微小的尘埃状颗粒,其形状和大小只能在显微镜下才能看到。
但是当成千上万的孢子聚集在一起时,你可以用肉眼看到它们的颜色,这有助于蘑菇的识别。
虽然蘑菇每天可以释放数十亿个孢子,但大多数孢子永远不会变成新的真菌,因为它们需要克服几个障碍。
孢子本身营养成分不高,因此必须落在营养丰富的环境中才能萌发。除了合适的营养来源外,它们还需要特定的环境条件才能生长,包括适宜的温度范围和湿度。

蘑菇孢子的大小和形状因物种而异,但本质上是不运动的单细胞,具有坚实的细胞壁。
它们的细胞壁具有独特的结构,包含复杂的多糖网络,包括葡聚糖、几丁质和糖蛋白。
它异常坚韧,能够保护孢子免受极端环境条件的影响,包括过热、过冷、盐、过高或过低的 pH 值以及紫外线辐射。
尽管科学家们一直在研究孢子及其细胞壁,但它们仍然相对不为人知,还有很多东西需要学习。

蘑菇是真菌的子实体,它们产生孢子,使真菌能够传播到新的地方并进行繁殖。蘑菇具有由孢子菌丝构成的孢子产生结构或表面。这些特殊的菌丝产生孢子。
在有菌盖的蘑菇中,孢子产生面通常位于菌盖的内侧。菌盖就像一把伞,保护菌盖内部的结构和孢子免受雨水和过多阳光的侵蚀。
产生孢子的结构因物种而异,但最常见的有鳃、孔或齿。
许多著名的食用蘑菇都有菌褶,包括白蘑菇、褐蘑菇、波托贝罗蘑菇、平菇和香菇。
受欢迎的有孔蘑菇的例子有备受追捧的牛肝菌,以及灵芝和云芝等药用蘑菇。
所有蘑菇中最奇特的要数那些菌褶不是由菌丝而是由菌齿或菌针组成的蘑菇了。例如,猴头菇和刺猬菇就是这类蘑菇。
虽然菌褶、菌齿和菌孔是最常见的孢子产生结构,但也有一些蘑菇以其他方式产生孢子,包括鸡油菌、马勃和羊肚菌。
我们关于蘑菇各部分的文章里有更多信息供您参考。

真菌产生孢子的主要原因是传播和寻找新的食物来源,但它们也利用孢子来创造新的菌株,确保物种的生存。
虽然许多真菌既可以进行无性繁殖,也可以进行有性繁殖,但当两个不同亲本真菌的孢子在有性繁殖过程中结合时形成的新物种通常更具适应性。
来自不同亲本真菌的综合特性使它们在不太有利的环境中拥有更大的生存机会。
一朵蘑菇就能释放数十亿个微小的孢子,这些孢子会通过风、水、昆虫或动物传播。许多孢子永远不会发芽,但那些落在腐烂有机物中的孢子则有机会发芽。
它们可以保持休眠状态,直到环境条件适合萌发,然后产生丝状菌丝,找到并与相反类型的交配菌丝融合,形成新的菌丝体。

一般来说,蘑菇孢子不会对人体造成伤害。当你食用美味的食用蘑菇时,通常也会同时摄入一些孢子,这些孢子会顺利地通过你的消化系统排出体外。
我们呼吸的空气中还含有许多微小颗粒,包括细菌、灰尘、花粉和真菌孢子,这些通常对大多数人来说不是问题。
但吸入蘑菇孢子确实会引起某些人的过敏反应,尽管据估计,只有极少数人对真菌孢子过敏。
少量蘑菇孢子通常无害,但反复接触大量孢子则更危险,可能引起炎症和过敏症状。
如果你是蘑菇种植者,经常接触大量孢子,建议佩戴呼吸器。但对于不常接触孢子的种植者来说,这通常不是问题。
有些蘑菇品种比其他品种产生更多的孢子。平菇和香菇就是其中的代表,最好在它们释放孢子之前采摘。
不同品种的蘑菇最佳采摘时间各不相同。但一般来说,当菌盖开始展开但边缘仍然向内卷曲时,采摘效果最佳。
蘑菇孢子印是一种图案,通常制作在纸张、锡箔或玻璃上。这种图案是由成千上万的孢子在无风的地方从蘑菇的孢子表面垂直落下形成的。
研究人员将蘑菇孢子印制在玻璃载玻片上,以便在显微镜下研究孢子,从而了解更多信息。真菌学家通常将蘑菇孢子印制在锡箔纸上,以便收集孢子并培育新的或有趣的物种。
有些人还会将蘑菇孢子印在纸上进行艺术创作。
每一张孢子印都独一无二、美丽动人,但也十分脆弱。制作孢子印时务必小心谨慎,因为即使是最轻微的气流也会吹动微小的孢子,使图案模糊不清。

人们通常将蘑菇孢子用于以下三个方面:
在鉴别蘑菇时,孢子起着重要的作用,因为它们具有独特的颜色、形状和大小。
许多采摘者会根据成熟蘑菇菌褶的颜色(通常也与孢子颜色相同)来辅助识别。但有时最好还是把蘑菇带回家,制作蘑菇孢子印,以便准确观察孢子的颜色。
这在一定程度上有所帮助,但好几种蘑菇的孢子颜色都一样。通常情况下,要百分之百确定你拥有的是哪种蘑菇,唯一的办法就是在显微镜下观察孢子。
我们大多数人都没有显微镜,所以最好在有经验的人的带领下去采摘蘑菇,同时学习如何识别可食用的品种。
蘑菇识别应用程序也能帮助识别蘑菇,但除非你 100% 确定蘑菇的身份,否则千万不要食用。

你可以用孢子注射器在家种植蘑菇,享受种植的乐趣。
孢子注射器顾名思义,就是一个装有悬浮在无菌水中的孢子的注射器。它通常用于接种已灭菌的谷物,以制备谷物菌种。
虽然用孢子培育蘑菇很有趣,但结果难以预测。因为每次两个孢子融合都会产生一个具有新特征的新菌株,所以无法保证最终会得到什么样的蘑菇。
从孢子开始培育蘑菇也需要更长时间,因为你是从蘑菇生命周期的最初阶段开始的。而且,增加培育步骤也会增加过程中出现问题的概率。
商业和小规模农户通常使用含有从成熟物种克隆的菌丝体的蘑菇培养物或菌种来种植蘑菇。
大自然充满了美丽的图案。几个世纪以来,艺术家们一直利用花朵和树叶进行艺术创作,如今他们也开始利用蘑菇孢子印来创作装饰艺术品。
如果你住在蘑菇很多的地区,孢子印画是一个可以在家尝试的有趣项目,你可以尝试不同的蘑菇和不同类型的纸张。
处理不知名的蘑菇时务必小心,因为它们可能有毒。务必戴上手套,并且不要将任何野生蘑菇放在儿童或宠物能够接触到的地方。

我们对真菌及其菌丝体仍有很多需要了解的地方,科学家们在探索这些非凡生物材料的过程中不断取得新的发现。
少量孢子对大多数人来说不是问题,但如果您经常接触菌丝体材料,建议在通风良好的环境中进行创作,以获得更舒适的体验。
如果您是初次尝试菌丝体材料DIY,可以在作品成型后及时使用或保存,既能保持作品的最佳状态,也能更好地体验这种独特材料的创作乐趣。